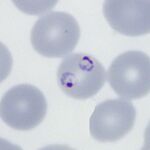
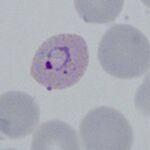

Gallery of early trophozoites
From haematologyetc.co.uk
Navigation
Go Back
General Comments: At the very earliest point all trophozoites appear as ring forms and species differences are very difficult to distinguish - some "species specific" features may appear as parasites mature toward late trophozoite stages.
P.falciparum
Small delicate rings, that may be the only forms seen in some patients at diagnosis. Red cells have normal (or slightly crenated) appearance.
"
P.vivax
Rings begin as small forms, but become larger within enlarged distorted red cells as they develop. Scuffner's dots will become present
"
P.ovale
As with the other species development begins with small forms and normal red cells; However as the species develops cahnges to red cells begin that might include fimbriation, ovoid form and some enlargement. Similar to P.vivax the cytoplasmic James (Schuffners) dots appear initially as a fine dots but becoming more prominent as the parasites mature.
"
P.malariae
Generally parasites are infrequent. The very early small forms become a little more robust than P.falciparum, and may acquire features more typical (though not exclusive) for species including central chromatin dot forms, and early parasite elongation or angular forms. Red cells have normal size and shape or may have reduced size, cytoplasmic dots should not be present (although the uncommon fine Stinton's dots may be seen).

Early elongation, Stinton's dots
"
P.knowlesi
At the early trophozoite stage an infection by P.knowlesi resembles that of P.falciparum and the number of infected cells amy be high. Forms found may also resemble P.falciparum with parasites that have double chromatin dots, multiply infected red cells, or accolé forms. This may create diagnostic difficulty in cases where only early trophozoites are present. Later forms however begin to resemble parasites of P.malariae and these should be specifically sought where infections arise in geographical areas associated with this parasite.